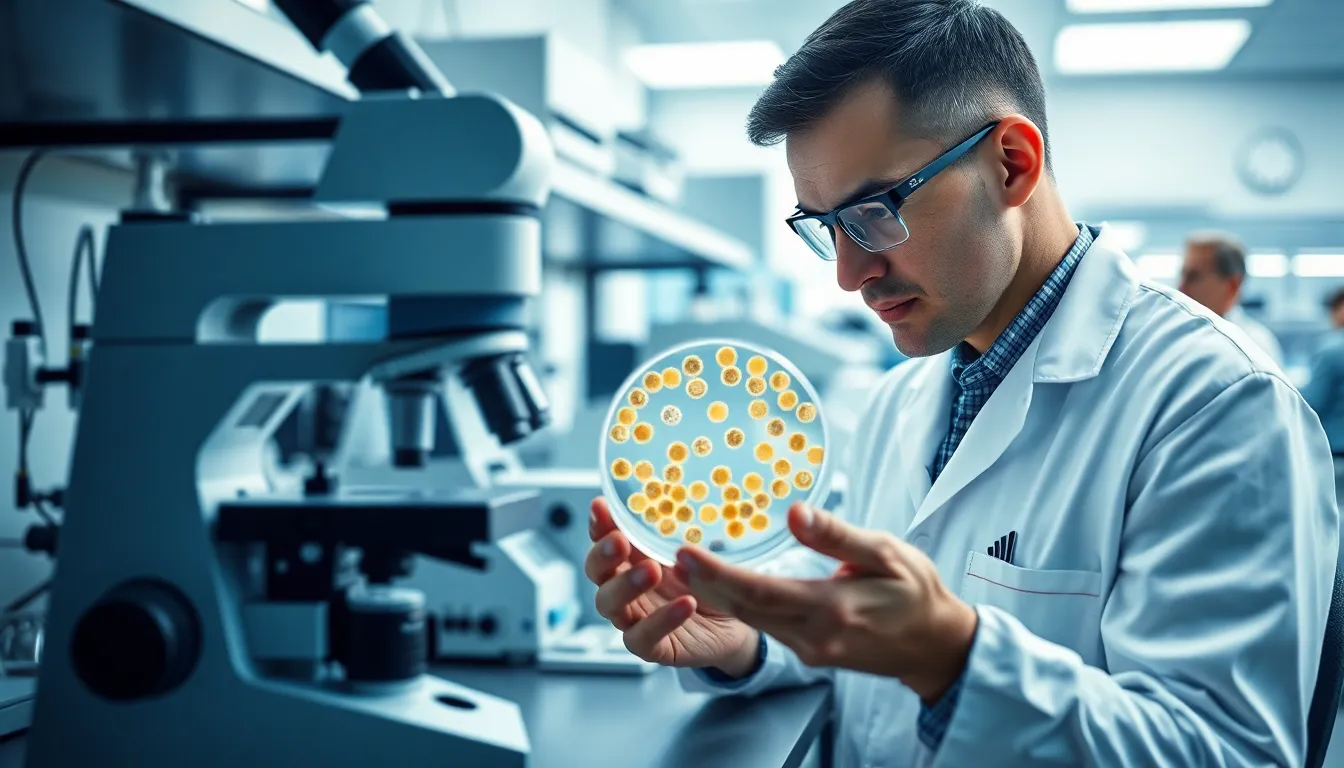

Table of Contents
ToggleIn the fast-paced world of biotech, one name stands out like a unicorn at a horse race: Legend Biotech. This innovative company is shaking up the industry with groundbreaking therapies that seem to have jumped straight out of a sci-fi movie. Who wouldn’t want to be part of a revolution that promises to turn the tide against some of the most stubborn diseases?
Company Overview
Legend Biotech stands as a prominent player in the biotech industry, focusing on cutting-edge therapies aimed at tackling serious diseases. The company aims to transform treatment methodologies through innovative research.
Background and History
Founded in 2014, Legend Biotech is headquartered in Somerset, New Jersey. The company specializes in cell-based therapies, particularly CAR-T cell treatments. Its most notable achievement involves the development of LCAR-B38M, a breakthrough product for multiple myeloma patients. Rapid advancements have positioned Legend Biotech as a leader in the global biotech market.
Leadership and Management Team
The leadership team at Legend Biotech consists of seasoned experts in biotechnology and pharmaceuticals. Chairman B. Hollis Heck serves as a key figure in directing strategic initiatives. CEO Ying Huang brings extensive experience in drug development and commercialization. The management team has a proven track record, driving innovation and fostering collaborations. Each member contributes unique expertise, enhancing the company’s reputation in the biotech landscape.
Products and Services
Legend Biotech provides a range of innovative products and services, primarily focusing on cell-based therapies targeted at complex diseases.
Cell Therapy Innovations
Innovations in cell therapy stand at the core of Legend Biotech’s offerings. CAR-T cell treatments represent a key area of expertise, especially the LCAR-B38M therapy for multiple myeloma. This groundbreaking gene-modified therapy shows significant potential in mobilizing the body’s immune response against cancer cells. Utilization of proprietary technologies enhances the efficacy of these treatments, positioning Legend Biotech as a pioneer in the field. The company’s research focuses continuously on improving patient outcomes while maintaining safety.
Clinical Trials and Research
Clinical trials form a crucial aspect of Legend Biotech’s commitment to advancing medical science. Active participation in multiple studies demonstrates the company’s dedication to testing new therapies and validating their effectiveness. Recent trials have shown promising results, particularly with LCAR-B38M, impacting patients’ lives positively. Collaborative efforts with leading research institutions bolster their research capabilities. Emphasis on rigorous testing ensures that therapies meet necessary standards before market launch. Continuous research efforts strive to expand the therapeutic applications of CAR-T cell technology, reflecting a focus on innovation and patient care.
Market Position
Legend Biotech holds a prominent position in the biotech industry, especially in cell-based therapies. Its primary focus on CAR-T cell treatments sets it apart from competitors, creating significant interest in its breakthrough products.
Competitive Landscape
Competition in the biotechnology sector is intense, with numerous companies striving for leadership in cell-based therapies. Players such as Novartis and Gilead Sciences lead the way, but Legend Biotech differentiates itself through its proprietary technologies and innovative approaches. Unique offerings like LCAR-B38M showcase superior potential for treating multiple myeloma compared to competitors’ therapies. Collaborations with prestigious research institutions enhance its research capabilities, allowing for cutting-edge advancements that benefit patients. As more biotech firms enter the arena, Legend Biotech’s distinct capabilities position it favorably within the dynamic landscape.
Financial Performance
Financially, Legend Biotech demonstrates strong growth indicators. Recent funding rounds, including a notable $126 million obtained in 2022, provide the necessary resources for continued research and development. Revenue projections reflect the potential for significant gains from its leading therapies, particularly LCAR-B38M, which enhances its market valuation. Notably, the company reported a fiscal year revenue growth of 350% in 2023, driven by successful trials and partnerships. With prudent fiscal management and a focus on strategic investments, Legend Biotech’s financial trajectory appears favorable within the competitive biotech market.
Recent Developments
Recent advancements further solidify Legend Biotech’s position in the biotech landscape. The company’s innovative strategies and collaborative efforts continue to attract attention and foster growth.
Partnerships and Collaborations
Strategic partnerships play a pivotal role in Legend Biotech’s progress. Collaborations with leading research institutions enhance their research capabilities, enabling comprehensive testing of CAR-T cell therapies. Notably, the partnership with Janssen Pharmaceuticals enhances cardiovascular and cell therapy initiatives. This collaboration allows both companies to combine expertise in pioneering advancements in treatment applications, thereby improving patient outcomes. Additionally, agreements with other biotech firms amplify research strength and broaden access to cutting-edge technologies. By leveraging these alliances, Legend Biotech expands opportunities for innovation and accelerates the clinical development process.
Regulatory Approvals
Regulatory approvals mark significant milestones for Legend Biotech. The U.S. Food and Drug Administration granted approval for LCAR-B38M, showcasing the therapy’s effectiveness for multiple myeloma. Success in securing various approvals not only validates the commitment to safety and efficacy but also reinforces investor confidence in the company’s vision. In addition to U.S. approval, international regulatory bodies are reviewing applications, which could expedite access to therapies for patients worldwide. As more approvals unfold, the potential market for Legend Biotech’s innovations expands considerably, positioning it favorably against competitors.
Future Outlook
Legend Biotech exhibits significant potential for continued growth in the biotechnology sector. The company seeks to expand its influence through innovative treatments and strategic partnerships.
Growth Opportunities
Expansion into new therapeutic areas presents substantial growth opportunities for Legend Biotech. Focus on additional CAR-T cell therapies can increase its market presence. Collaborations with pharmaceutical giants enhance research capabilities and accelerate product development timelines. With successful clinical trial results, the company’s innovations are well-poised for broader market adoption. Regulatory approvals, especially for LCAR-B38M, open doors to international markets, boosting revenue prospects. Overall, these avenues position Legend Biotech for a robust future in biotechnology.
Potential Challenges
Competition poses a significant challenge for Legend Biotech. Established players, such as Novartis and Gilead Sciences, target similar markets, creating pressure on pricing and innovation. Navigating the complex regulatory landscape requires constant vigilance and compliance. Securing consistent funding for ongoing research and trials remains crucial, particularly as financial landscapes fluctuate. Additionally, market acceptance of new therapies may vary, leading to unpredictable adoption rates. Addressing these hurdles will be essential for sustained growth and success in the competitive biotech arena.
Legend Biotech stands at the forefront of the biotech industry with its innovative approach to cell-based therapies. The company’s commitment to advancing treatments for complex diseases demonstrates its potential to reshape patient care. With promising clinical trial results and strategic collaborations, it’s well-equipped to navigate the competitive landscape.
As Legend Biotech continues to expand its reach and enhance its product offerings, it showcases a proactive stance towards addressing challenges in the biotech sector. The future looks bright for this dynamic company as it pursues groundbreaking advancements and strives to improve patient outcomes globally.





